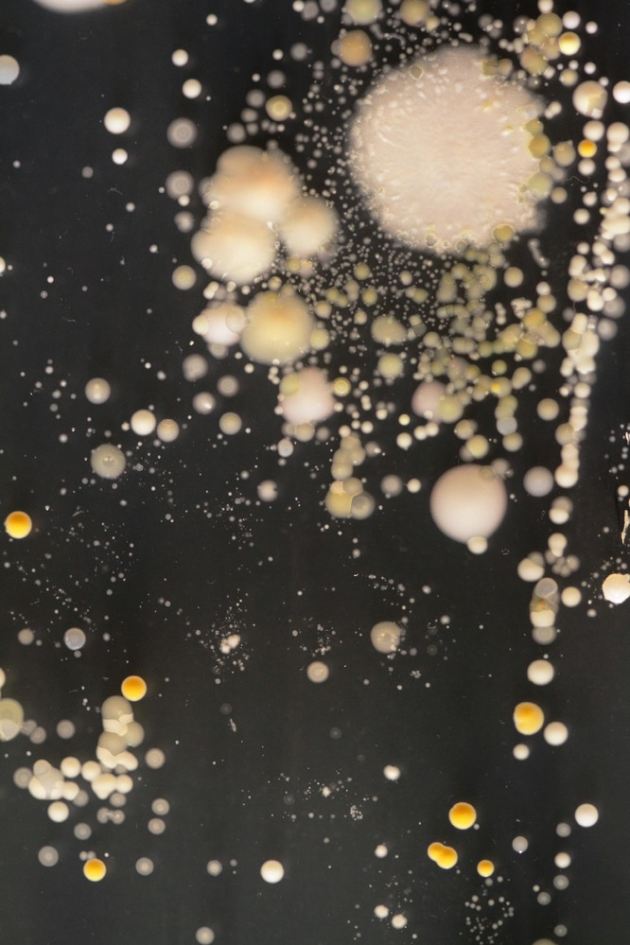
slide_282519_2137998_free
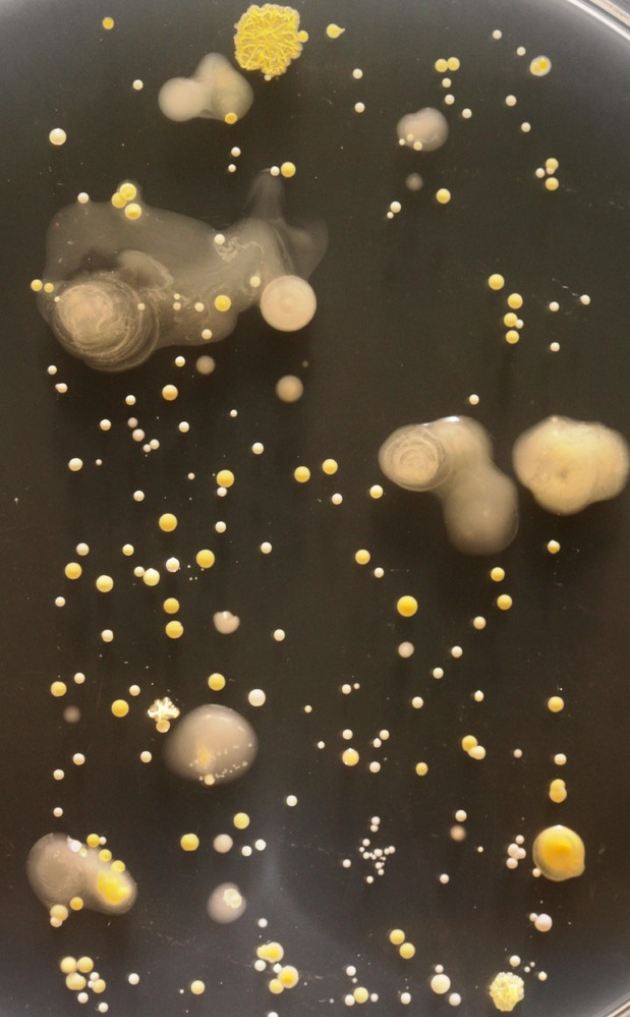
slide_282519_2138010_free
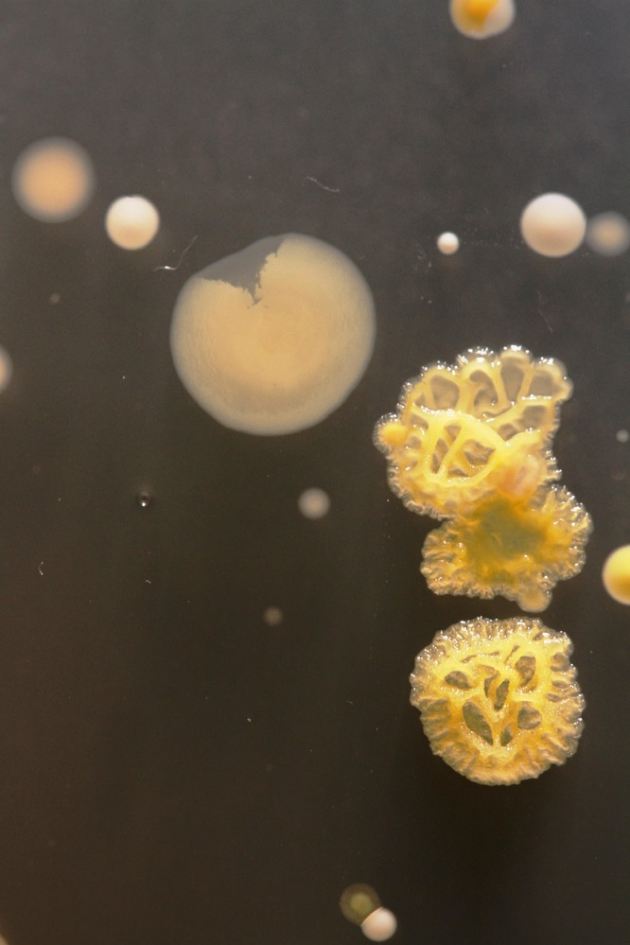
slide_282519_2138000_free
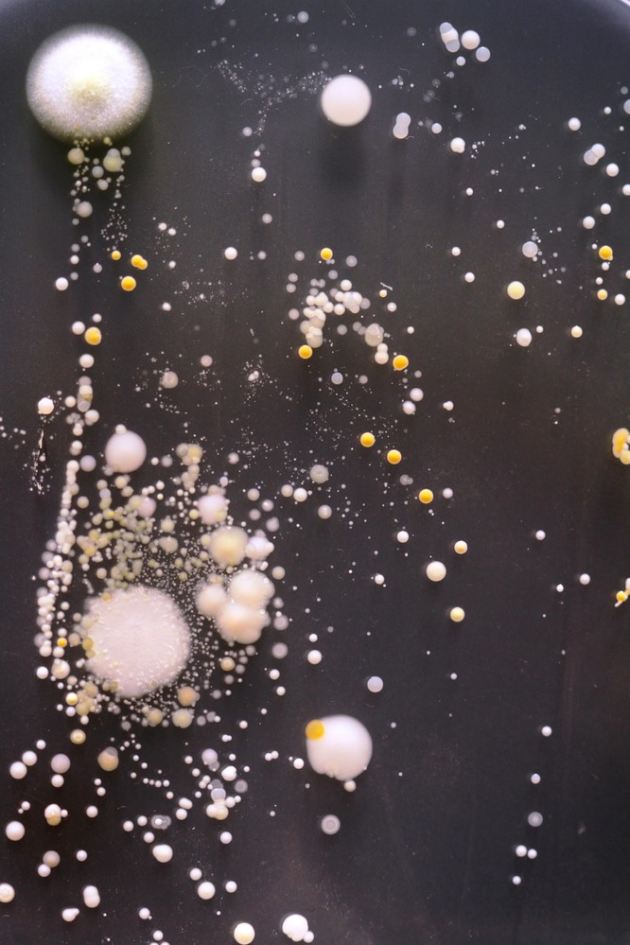
slide_282519_2137997_free

ดร. ไซมอนปาร์คอาจารย์อาวุโสภาควิชาอณูชีววิทยาที่มหาวิทยาลัยเซอร์เรย์ ประเทศอังกฤษ ได้ทำการทดลองนำเอาหน้าจอมือถือของนักเรียนที่ใช้งานอยู่เป็นประจำไปวางประทับหน้าจอกับจานเพาะเชื้อเพื่อทำการทดสอบการเจริญเติบโตของแบคทีเรียเป็นเวลา 3 วัน เพื่อให้นักเรียนได้เห็นว่าหน้าจอมือถือนั้นสกปรกแค่ไหน ซึ่งผลลัพธ์ที่ได้นั้นทำให้เห็นว่าพบเชื้อแบคทีเรียหลายชนิดเลยทีเดียว
แม้ว่าภาพแบคทีเรียที่เห็นนั้นจะดูน่ากลัวมากแต่ก็ไม่มีสายพันธุ์ที่เป็นอันตรายต่อมนุษย์ จึงมีคำถามตามออกมาว่า แล้วเราต้องป้องกันอย่างไร จำเป็นต้องถึงขนาดใส่ถุงมือเพื่อใช้งานหน้าจอมือถือหรือไม่? โดย ดร.ไซมอนปาร์คให้ความเห็นว่าแค่หมั่นทำความสะอาดมือถืออย่างน้อยสัปดาห์ละครั้ง และทางที่ดีก็ไม่ควรที่จะนำมาถ่ายรูปบนโต้ะอาหาร หรือวางมือถือใกล้กับจานอาหารในแต่ละมื้อก็เพียงพอแล้ว
http://www.flashfly.net/wp/?p=111631